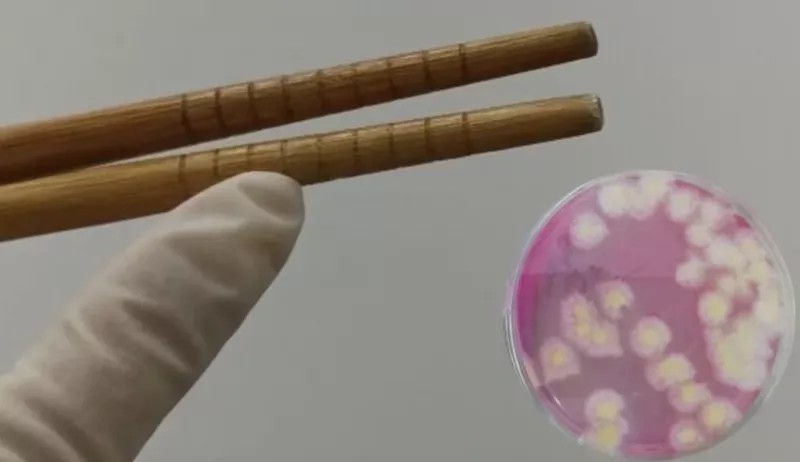

说到广东人的“饮食迷惑行为”
不得不提到
餐前用茶开水烫筷子
那么
这种给筷子消毒的方法有用吗?
木筷、竹筷、不锈钢筷子……
哪种容易发霉?
近日
上海市消保委对860双不同材质
包括木、竹、不锈钢、密胺合金等
五类筷子进行专项测试
结果可能让你大吃一惊
竹木的、使用时间超6个月的筷子
更容易发霉
不同材质的筷子,哪种更容易发霉?本次测试征集了200双普通家庭使用过的旧筷子和660双新筷子,样品材质包括木、竹、不锈钢、密胺、合金等五类。具体测试时,工作人员将清洗后擦干和未擦干的状态下,模拟不同环境,观察筷子上霉菌数量的变化。

测试结果显示:
湿筷子的霉菌比干筷子多25%以上。
不同的环境湿度下,筷子上的霉菌数量增长相差甚远。
其中,霉菌在湿度80%的条件下(如南方地区的梅雨季节)极易生长,而在湿度40%的条件下基本不生长。温度对霉菌生长的影响不大。
另外,旧筷子、竹木筷更容易发霉。测试结果显示:使用时间超过6个月的筷子更容易长霉,霉菌数量比新筷子和使用3个月的筷子要多30%以上。木质和竹质筷子结构疏松,表面的凹槽、细纹容易藏匿细菌,竹木筷的霉菌计数是不锈钢、合金、密胺筷的7倍以上。
提醒消费者
存放筷子要干燥
筷子存放要注意保持环境干燥。筷子在湿度大时极易发霉,建议在湿度大的环境下,如梅雨季,最好能用除湿机降低室内空气湿度以防止发霉。
“用沸水烫一下筷子”
做法基本没用
如何对筷子进行消毒?哪种消毒方式效果更好?消委会本次测试,对酒精、微波炉、高压锅、沸水、臭氧消毒柜等方式进行消毒效果比较。结果显示:
酒精对霉菌基本没有作用;
微波炉虽然消毒时间最短(3分钟),但只能用于合金筷;
五类筷子都可通过高压锅、沸水、臭氧消毒柜来消毒,只是所用消毒时间略有差异。
老广喜欢“洗刷刷”对筷子冲洗消毒效果怎么样?测试结果显示:
“用沸水烫一下筷子”的做法基本没用,只有当消毒时间超过20分钟,筷子上的菌落和霉菌才能被有效去除。
五类筷子中,不锈钢、合金、密胺筷更易消毒,木筷、竹筷稍差。
筷子最好每周进行一次消毒,养成勤换筷子的习惯,最好半年换一次。

五类筷子在五种消毒方式下的适用性和对霉菌的消毒效果
清洗是否干净,也是影响筷子消毒效果的重要因素。在相同的消毒方式下,洗干净的筷子消毒效果更好,菌落和霉菌数量要比未清洗的筷子少80%以上。
因此,消委会提醒清洗筷子不仅能洗掉筷子上的食品残渣和油污,同时也能洗掉筷子上残存的部分微生物。建议养成饭后即清洗筷子的习惯,且要慢慢仔细清洗。清洗后把筷子放在碗架上散开晾干或者用专用的擦筷子布擦干再把筷头朝上放进筷笼。
外出就餐
消毒餐具卫生情况怎么看?

市民在日常使用消毒餐具时,可以记住“三要三无”,来对餐具的卫生进行初步判断。

网友评论:
入乡随俗 ,这是广东人最后的倔强!
不烫一下不知道怎么开始吃饭
烫的是一种仪式感!

烫的是心理安慰!
